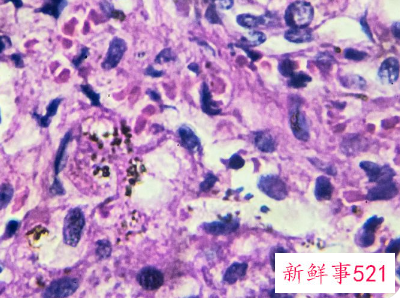
霉菌用手抠出来的图片

微信扫码关注霉菌用手抠出来的图片
霉菌用手抠出来的图片,霉菌主要是属于一种传染性的疾病, 也是由一种念珠菌引起的常见多发的外阴阴道炎症性疾病,那么你们知道霉菌用手抠出来的图片都有哪些吗。
霉菌用手抠出来的图片1 霉菌在生活中无处不在,比较青睐于温暖潮湿的环境,一旦有合适的环境,就会大量繁殖,而受霉菌感染的女性占比很大,以YD为主,另外口腔、耳朵等都有可能出现霉菌感染。女性外阴处于一个自然闭合的状态,而使用不洁的马桶、浴盆、毛巾或卫生纸等,都会感染霉菌,加上这温暖的环境,就会大量繁殖。
霉菌达到一定数量时,就会出现霉菌性外阴YD炎,所以需要保持卫生才能够避免,而出现YD炎,有些女性不太懂,就会用手扣,通过霉菌用手抠出来的图片会发现,抠出来的霉菌呈豆渣样分泌物,但这样的行为是非常不可取的。

YD一旦出现霉菌,单纯用手抠,是没办法完全抠干净的,而且也很不卫生,容易加重炎症的发生。正常来说,一旦出现霉菌感染而引发YD炎,自行排除都比较难,需要进行YD冲洗,可以在医用让医生用碘伏进行清洗和杀菌,也可以自己买冲洗器冲洗。
霉菌属于真菌感染,有一定传染性,所以一定要保持清洁,注意换洗。在进行治疗的同时,还要禁止X生活,以免传染给对方。在霉菌感染不严重的情况下,用药只需要2-3天即可痊愈,较严重的一般一周内也基本可以好。
要知道不仅是霉菌用手抠出来的图片呈豆渣样,其实一旦出现霉菌性YD感染,大多都会伴有分泌物,也是呈豆腐渣样,而且还会出现外阴瘙痒,出现症状后,千万不要用手扣,直接去医院进行检查治疗,避免加重炎症。
霉菌用手抠出来的图片2 霉菌用手抠出来非常不可取的,会导致感染。
霉菌性阴道炎用手抠出来是豆腐渣样的分泌物,建议不要用手抠,容易感染,冲洗阴道的时候可以把豆腐渣样白带冲出来,注意不要过度掏洗。治疗期间要注意冲洗阴道每周1次为宜,以免造成菌群失调。
霉菌性阴道炎是由念珠菌引起的一种常见多发的外阴阴道炎症性疾病。白色念珠菌为条件致病菌,10%~20%的'非孕妇女及30%的孕妇阴道中有此菌寄生,但菌量少,不引起症状。只有当全身及阴道局部免疫能力下降,白色念珠菌大量繁殖,才会引发阴道炎症状。
对单纯性外阴阴道念珠菌病选择局部用药为主,一般用药后2~3日症状减轻或消失。克霉唑阴道栓,隔3日用,共2次。关于复杂性外阴阴道念珠菌病的治疗,选择的药物基本同单纯性外阴阴道念珠菌病,无论局部用药或全身用药,均应适当延长治疗时间。
霉菌用手抠出来的图片3 霉菌性阴道炎是什么原因引起的
导致霉菌性阴道炎的原因很多,有可能是免疫力下降,也有可能是通过性生活传播的,也有可能是平时用多了抗生素造成了阴道菌群平衡失调等等一系列的原因都会造成霉菌性阴道炎。
霉菌性阴道炎症状表现
霉菌性阴道炎的典型症状是外阴瘙痒,而且瘙痒有的时候症状比较严重,有的时候症状又比较轻,瘙痒严重时还会影响正常生活。炎症较重时可能出现排尿痛、性交痛等。白带增多是本病的另一主要症状,白带一般很稠,呈豆渣样或乳凝块状。

霉菌性阴道炎的治疗方法
霉菌性阴道炎的治疗因情况不同而异,具体可从以下三个方面来说:
(1)对单纯性外阴阴道念珠菌病可以进行局部用药,一般用药后2-3日症状减轻或消失。克霉唑阴道栓,隔3日用,共2次。
(2)关于复杂性外阴阴道念珠菌病的治疗,选择的药物基本同单纯性外阴阴道念珠菌病,可以适当延长用药时间。
(3)妊娠期外阴阴道念珠菌病的治疗原则为:治疗时必须考虑的首要问题是药物对胎儿有无损害;治疗以局部用药为主,不予全身用药;仅限于有症状和体征的孕妇。
霉菌性阴道炎日常护理注意事项
如果已经确诊是霉菌性阴道炎,建议尽快用药治疗阴道塞制霉菌素泡腾片,用小苏打溶液冲洗阴道,治疗期间内裤要消毒,暂时不能同房,不要熬夜,增强免疫力。一般治疗好的有效率达80%~90%,但是复杂性外阴阴道念珠菌病易复发。
在生活当中,大家一定要注意卫生,预防阴道炎的发生,要积极锻炼身体,均衡饮食,不过食含糖量高的食品;要养成良好的卫生习惯;要合理穿衣,避免长时间紧身衣,对身体造成负担;使用公共厕所时尽量避免坐式马桶;提倡淋浴;不滥用抗生素;对于糖尿病患者要积极治疗糖尿病;对于药物避孕的妇女来讲,如果反复发生念珠菌性阴道炎,应停用避孕药,改用其他方法进行避孕。
推荐阅读
❤️你向往的林荫小道早已车水马龙❤️肏出来的泪水、高潮
❤️你向往的林荫小道早已车水马龙❤️肏出来的泪水、高潮时的泛红和颜射后的精液 绝对是女人最好的化妆品
2025-12-25
被单男的大鸡吧插进骚逼的时候,我是很排斥老公把他的小鸡
❤️淫妻狂魔❤️被单男的大鸡吧插进骚逼的时候,我是很排斥老公把他的小鸡吧放进我嘴里的,但是被单男操到失神以后就不管鸡吧的大小了,嘴里能吃到鸡吧就行
2025-12-25
❤️我能想到最浪漫的事,就是和你试遍所有姿势❤️哥哥能
❤️我能想到最浪漫的事,就是和你试遍所有姿势❤️哥哥能抓着衣服把我按在椅子上肏 像野S一样野蛮 不断向哥哥求饶都不停
2025-12-25
❤️可爱福利姬❤️白里透红的身姿,娇羞可爱的表情,粉嫩
❤️可爱福利姬❤️白里透红的身姿,娇羞可爱的表情,粉嫩紧闭的小穴是如此的耀眼夺目 致敬全网可爱女宝贝,因为有你们,网络从此多姿多彩
2025-12-25
【极品稀缺孕妇也疯狂】❤️性孕之美❤️全系列孕妇啪啪、
【极品稀缺❤️孕妇也疯狂】❤️性孕之美❤️全系列孕妇啪啪、自慰、喷奶自拍甄选 反正怀孕随便内射
2025-12-25
推荐文章